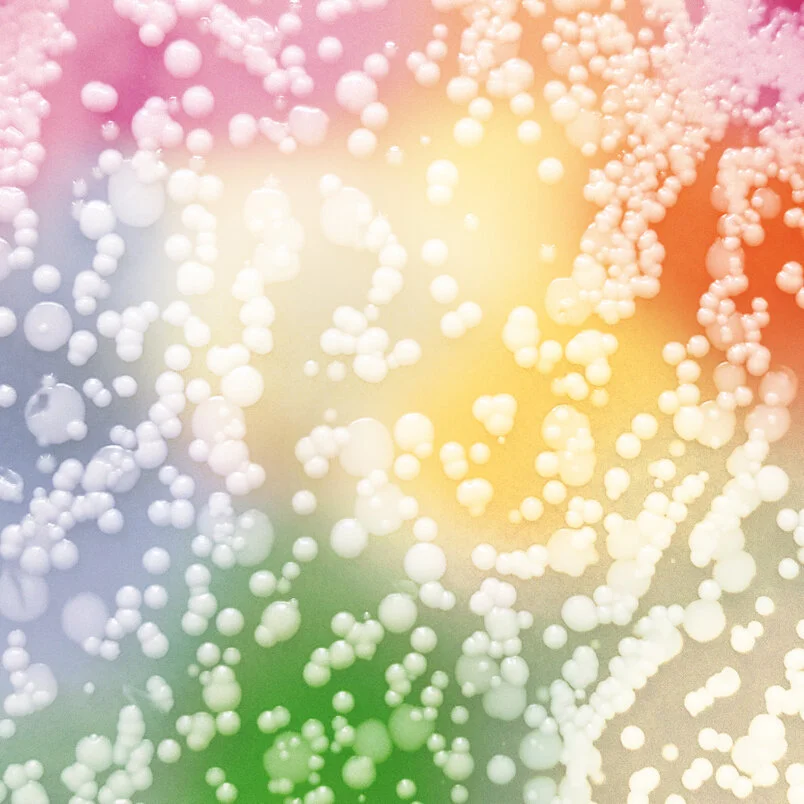
5f5e22e9d9024c768a0f4bfb_1.jpeg

HQ: New York, NY
Founders: Kendall Dabaghi and Ravi Sheth
Website: kingdomsuperculture.com
Opportunity: Consumers demand evidence-based natural solutions for everyday health challenges. Kingdom creates and supplies Superculture® ingredients - a new class of clinically-validated postbiotics that target the root causes of unmet health needs. With verified stability and compatibility across all product types, Superculture® ingredients enable brands to make powerful new health claims backed by real science.
Vision: Kingdom's vision is to cultivate healthier living with natural ingredients that target root causes and deliver best-in-class clinical results.
Status: Active